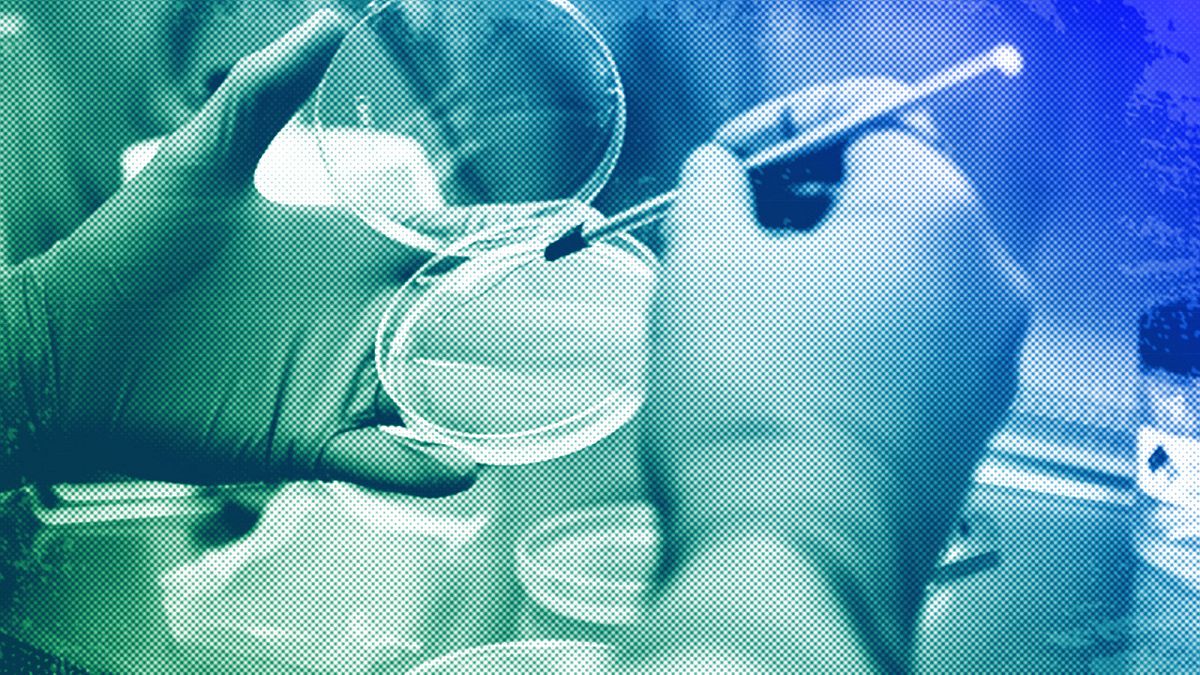
A technician culturing bacteria to study immune defence at NASA Ames Research Center in Mountain View, CA, December 2012

Nous avons le choix : être la génération qui prend des mesures décisives contre la résistance aux antimicrobiens, préservant ainsi notre santé et celle des générations futures. Ou être la génération qui a gâché l’opportunité qui s’offrait à elle, mettant potentiellement en péril la médecine moderne telle que nous la connaissons, écrit le Dr Hans Henri P Kluge.
Tout le monde connaît la pénicilline. C’est l’un des médicaments les plus prescrits au monde. Et c’est là que réside le problème.
La pénicilline est le premier antibiotique découvert en 1928. Elle a révolutionné les soins de santé. Désormais, les patients ne devaient plus mourir ni subir d’amputation à cause d’infections bactériennes bénignes.
Des millions de vies ont été sauvées et des dizaines d’autres médicaments antibiotiques ont été développés depuis.
Mais nous nous trouvons aujourd’hui à un tournant. Ces infections « mineures » sont à nouveau en danger de mort. De nombreuses infections deviennent plus difficiles à traiter, tandis que les procédures médicales, comme la chirurgie et la chimiothérapie, sont devenues beaucoup plus risquées.
Comment en sommes-nous arrivés là ?
Au cours des dernières décennies, de nombreuses bactéries ont évolué et sont devenues résistantes aux antibiotiques. Il s’agit d’un processus naturel qui se produit au fil du temps par le biais de modifications génétiques chez les bactéries.
Cependant, le processus est accéléré par l’homme en raison d’une utilisation inappropriée — comme lorsque vous arrêtez un traitement antibiotique avant la fin du traitement prescrit — et d’un diagnostic erroné, par exemple lorsque votre médecin vous prescrit des antibiotiques pour une infection virale sur laquelle les antibiotiques n’ont aucun effet.
C’est ce qu’on appelle la résistance aux antimicrobiens (RAM) et c’est l’une des plus grandes menaces pour la santé publique dans le monde aujourd’hui.
Les avancées médicales réalisées au cours du siècle dernier sont en train d’être annulées sous nos yeux, mais cette « pandémie silencieuse » reçoit encore très peu d’attention en dehors du domaine de la santé publique.
Nous savons déjà que la résistance aux antibiotiques est directement responsable de plus d’un million de décès par an et indirectement liée à 5 millions de décès dans le monde. Pour mettre les choses en perspective, le fardeau sanitaire de la résistance aux antibiotiques est comparable à celui de la grippe, de la tuberculose et du VIH/sida réunis.
Dans la région européenne de l’OMS, qui couvre 53 États membres d’Europe et d’Asie centrale, la RAM est déjà directement responsable de 133 000 décès chaque année et indirectement liée à 541 000 décès. Et ces chiffres ne font qu’augmenter.
À ce rythme, si rien n’est changé, d’ici 2050, plus de 10 millions de personnes mourront chaque année dans le monde à cause de la RAM.
Nous avons un plan pour résoudre ce problème.
Alors que la crise de la RAM se développe rapidement, nous savons ce que nous devons faire pour y mettre un terme. L’année dernière, les 53 États membres de l’OMS/Europe ont adopté la feuille de route 2023-2030 sur la RAM, qui donne la priorité aux actions dans la région. Notre feuille de route a rassemblé les données disponibles sur les outils efficaces pour lutter contre la RAM.
Premièrement, nous devons réduire le nombre d’infections qui doivent être traitées avec des antibiotiques.
Cela signifie prévenir l’infection en premier lieu par des mesures de contrôle appropriées. Cela signifie également assurer des vaccinations systématiques, ainsi que de bonnes pratiques en matière d’eau, d’assainissement et d’hygiène, en particulier dans les hôpitaux et autres services de santé.
Deuxièmement, nous devons réduire l’utilisation des antibiotiques chez les humains, les animaux et dans l’agriculture.
Dans le cadre d’un programme global de gestion des antibiotiques, nous avons besoin de davantage de tests diagnostiques pour garantir un traitement ciblé. Les professionnels de santé ont besoin d’une formation et d’un soutien adaptés pour suivre les directives fondées sur des données probantes en matière de prescription d’antibiotiques.
Les antibiotiques essentiels à la médecine humaine doivent être utilisés avec prudence dans les secteurs vétérinaire et agricole, en reconnaissant que la santé humaine, animale et environnementale sont étroitement liées — une approche « Une seule santé ».
Troisièmement, nous devons nous tenir mutuellement responsables en nous fixant des objectifs clairs.
Des objectifs mesurables nous permettent de concentrer nos efforts et nos ressources sur des domaines clés, motivant ainsi les gouvernements, les prestataires de soins de santé et les organisations à agir.
Le Bureau régional de l’OMS pour l’Europe, en collaboration avec la London School of Economics, élabore actuellement le premier indice de responsabilité en matière de RAM pour l’Europe et l’Asie centrale, qui bénéficie déjà d’un large soutien de nos 53 États membres grâce à l’adoption de la feuille de route sur la RAM l’année dernière. L’OMS/Europe prévoit de lancer l’indice en 2025, afin d’évaluer les progrès réalisés en matière de RAM et d’aider les États membres dans leurs efforts de riposte.
Quatrièmement, nous avons besoin de partenariats – avec les gouvernements, les industries pharmaceutiques, agricoles et alimentaires, le monde universitaire et la société civile.
La plupart des grandes sociétés pharmaceutiques se sont retirées de la recherche et du développement d’antibiotiques, car ces derniers sont souvent moins rentables que d’autres médicaments. Mais de nouveaux antibiotiques sont absolument nécessaires pour enrayer la « menace catastrophique » de la résistance aux antimicrobiens.
Cependant, le seul financement de la recherche ne suffira pas à résoudre le problème de la RAM. Il faudra également renforcer l’engagement communautaire et la sensibilisation du public.
Que choisirons-nous de faire ?
Alors que nous nous dirigeons vers une réunion de haut niveau sur la RAM ce mois-ci, en marge de la 79e session de l’Assemblée générale des Nations Unies, j’appelle à un leadership, un engagement, une action et une solidarité accrus à l’échelle mondiale.
Nous avons le choix : être la génération qui prend des mesures décisives contre la RAM, préservant ainsi notre santé et celle des générations futures.
Ou être la génération qui a gâché l’opportunité qui s’offrait à elle, mettant potentiellement en péril la médecine moderne telle que nous la connaissons.
Le choix est évident.